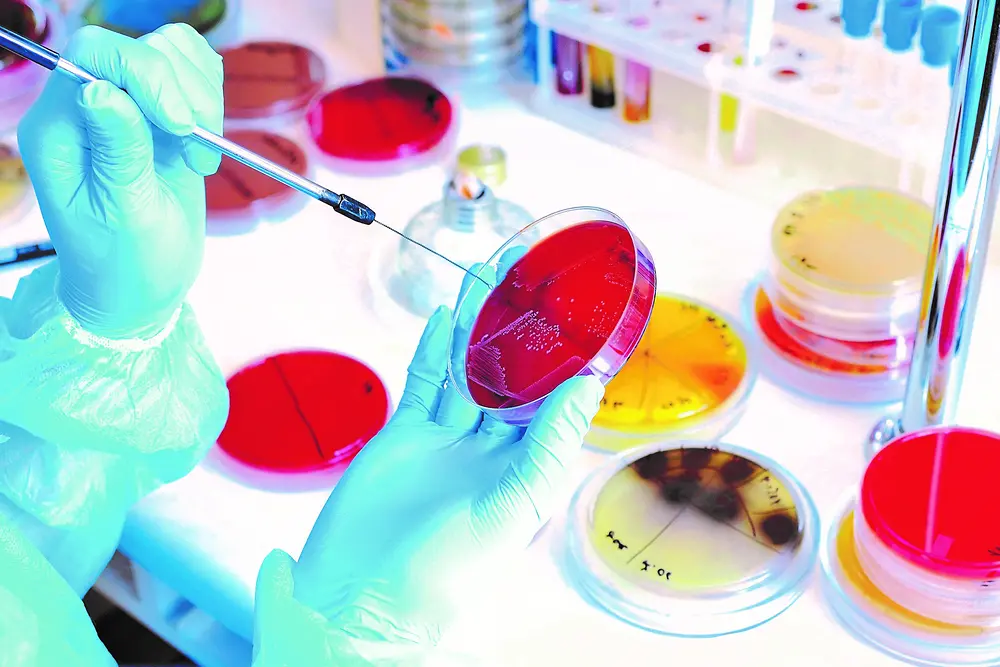

Expert knowledge and state-of-the-art measurement technology to support your business - Corporate Analytics offers a wide range of chemical and physical analyses from raw materials to end products. Which question can we support you with? Do you want to identify an unknown substance and determine its chemical structure, or are you interested in quantitative content determination? Do you need wet chemical key data of your raw materials, or is an ultra-trace analysis, for example the determination of volatile organic compounds or the nitrosamine content of interest? We determine the enzyme identity or activity as well as surfactant contents in your detergents and check the specified content of many ingredients in your products, by arrangement also in 24h Service. Our safety technology determines, among other things, data for material safety data sheets. Thermal analysis characterizes your material systems with regard to melting, boiling, evaporation, decomposition, but also elastic and plastic behavior. Numerous microscopic methods enable imaging surface and interface analysis. We provide you with comprehensive data on your substances for registration (REACH, biocides, polymers) also under GLP conditions and offer you the possibility of adequate method development and reliable method validation. You will find more details in the following sections.
Corporate Analytics


Corporate Analytics Topics
Structure determination and substance identification
All modern methods of molecular spectroscopy are available for the structural elucidation of organic substances. Not only 1H and 13C nuclei, but also various heteroatoms such as 31P, 29Si, 19F and 15N can be studied by nuclear magnetic resonance spectroscopy (NMR, up to 600 MHz), either in one-dimensional (1D), two-dimensional (2D) and also quantitative experiments.
Several other methods provide complementary information to NMR data, such as Raman and Infrared spectroscopy (IR) in different modes (attenuated total reflectance = ATR, microscopy, imaging/mapping) or Mass spectrometry (MS), the latter usually connected to a liquid or gas chromatographic separation system.
Depending on the complexity of the products to be analyzed, either the original substance or derived fractions are examined during the investigation. The identification is done via comprehensive spectral databases or via the interpretation of all different available data sources: Each structural proposal must be clearly supported by all the information obtained.
Ultra Trace Analysis
Corporate Analytics offers all methodologies for ultra trace analysis of organic and inorganic compounds in the lower ppb range and beyond.
For inorganic substances, ICP instruments with OES or MS detection enable sensitive and selective elemental screenings, either directly from the provided test solutions or – following sample preparation – from the digested sample material. Various digestion procedures (e.g., acid treatment, high pressure ashing, microwave treatment) are available.
Complex organic mixtures are typically separated using HPLC or GC systems. After that, the individual compounds are transferred into highly specific and sensitive mass spectrometric (MS) detectors. Whereas single-quadrupole mass spectrometers are the method-of-choice for timely and efficient analysis, more sophisticated triple-quadrupole and time-of-flight (TOF) mass spectrometers enable quantifications in the sub-ppb range as well as high-resolution mass (HR-MS) determination.
Special attention has to be paid to volatile organic compounds (VOC): via GC-MS the emission of small organic molecules during product application can be monitored, e.g., for automotive or aviation industry.
Product Analysis
Laundry detergents, cosmetics and chemical-technical products have become increasingly complex formulations.
Starting from general parameters like wet-chemical numbers, pH or CHN values, subsequent fractionation via extraction or ion exchange results in the breakdown of the used raw materials. The isolated fractions can be characterized by suitable chromatographic and spectroscopic techniques, resulting in a balance sheet of ingredients.
Besides chemical composition, further investigations may be required depending on the product type. For example, enzyme identity and enzyme activity are important parameters for premium laundry products.
Surface Analysis and Application Support
Quick troubleshooting is required, whenever products deviate from their specification or from their expected appearance. The list of possible deviations is long, such as discoloration, malodor, precipitation of ingredients or phase separation, just to name a few.
In some cases, these deviations can only be recognized in the application phase, which might adversely affect product performance and makes quick problem solving even more important.
The analytical methods of choice are as diverse as the problems to be tackled. Failures in surface treatment call for microscopic techniques like XPS, SEM/TEM, EDX, AFM, GD-OES or IR microscopy, giving valuable insight into oxidation state, elemental composition, morphology or organic impurities of the investigated material.
Deviations in product appearance might initiate a sequence of wet-chemical or chromatographic sample preparation steps: isolated particles or extracted discolored fractions may further be investigated and identified via IR, NMR or MS.
Food Safety and Certification
Food Contact Materials (FCMs) are all materials and articles intended to come into contact with food, e.g. packaging material or food processing machinery. FCMs may transfer their constituents onto the food, a process called migration.
To assess the transfer of substances onto food, migration is simulated in accelerated migration tests. For identification and quantification of migrating compounds a variety of analytical techniques is used. Besides screening procedures, also different specific methods like chromatography as well as spectroscopic methods are applied.
Following analytical testing, a Food Contact Certificate may demonstrate compliance with European and international food law, demonstrating consumer safety.
Further sensitive applications can be tested in the same way. Typical applications include medical products or products intended for skin contact.
Safety Technology and Thermal Analysis
The safe handling of hazardous substances is directly linked to a fundamental knowledge of their physical and chemical properties. Knowledge of the hazard potential is key to determining appropriate safety measures when handling these substances at each step of the product life cycle. Depending on the substance and the handling step, it may be necessary to perform dust fire and explosion characterizations, measure the hazard potential of chemical reactions, perform transport classification tests (e.g. ADR, RID), generate data for MSDS or product registration, or perform burning behavior tests, to name a few.
Thermal analytical methods such as differential scanning calorimetry (DSC), thermo-gravimetric analysis (TGA) and dynamic mechanical analysis (DMA) can be used to characterize substances and products in terms of melting, boiling, evaporation, curing, decomposition and also elastic and plastic behavior. Rheology can be used to make statements about flow behavior as a function of temperature, shear rate and other parameters. All this is essential for the manufacture, modification and use of materials as well as production parameters.
If required, internationally recognized quality standards such as Good Laboratory Practice (GLP) or DIN EN ISO/IEC 17025 are applied. This means that Corporate Analytics' test results are valid for worldwide product registration processes, e.g. REACH.
Registration of Chemical Substances and Products
Registration of chemical substances on regional or global level is a well-defined process (e.g. REACH legislation in the European Union), which enables the manufacturers to lawfully place their products on the respective market.
Besides general registration of chemicals, specific legislation is applicable to certain product categories (e.g. biocides) that call for specific test protocols (e.g. 5-batch analysis, SANCO/3030/99), adequate method development and reliable method validation.
A comprehensive data set has to be generated for each substance to be registered. Starting with investigations on identity and purity, a whole set of spectroscopic and chromatographic techniques is needed to acquire and to confirm compositional information.
Further substance specific properties like melting point, water solubility, surface tension or partition coefficient are determined following standardized OECD test guidelines.
If required, internationally recognized quality standards like Good Laboratory Practice (GLP) or DIN EN ISO 17025 are applied. Thus, the study results of Corporate Analytics are valid for global product registration processes, e.g. REACH.
Quality Control
Basically, all methodologies used for R&D support, product analysis or failure analysis can also be applied to establish a meaningful set of QC methods.
Wet-chemical values obtained by titration, such as acid values, OH values or amine values, and further sum parameters like water content according to Karl Fischer (KF) or nitrogen numbers (Kjeldahl) are suitable reference parameters.
Thin layer chromatography (TLC) is a powerful tool to obtain a quick overview of the raw materials used in a formulation. Residual amounts of monomers or other small molecules like e.g. preservatives or volatile organic compounds (VOC) can be monitored effectively with suitable liquid or gas chromatographic techniques.
Gel permeation chromatography (GPC) is the method of choice whenever the molecular weight distribution of (pre-)polymers and oligomers needs to be checked or fractions need to be quantified.
Quality control (QC) is an integral part of production processes, ensuring the product to meet the required specifications. Corporate Analytics is available to support with measurements or method developments.
Site Services
Control of Measuring Equipment
Quality relevant lab instruments for testing - like analytical balances, pipettes or thermometers - need to be controlled regularly to comply with applicable quality standards (e.g. DIN EN ISO / IEC 17025).
Corporate Analytics ensures retraceability of the test equipment to national reference standards, fulfilling the requirements for lab accreditation or lab certification. Additional support can be provided to the users, such as documentation, training and audit preparation.
Sound and Vibration Surveillance
Production processes and logistics are a potential source of harmful noise and vibration events, impacting safety and health of employees and environment.
Corporate Analytics is monitoring sound emissions at the Düsseldorf site from the premises and is maintaining noise cadasters. Noise areas and noise control levels for plant staff are evaluated and documented, giving advice and support how to establish noise reduction programs.
Corporate Analytics Techniques
Chromatography
GC, HPLC/UPLC, GPC/APC, IC and TLC systems with various injection (HS, TDS, TDU) and detection capabilities, 2D chromatography
Mass spectrometry
Sensitive organic trace analysis and structural determinations, iontrap/ triplequad MS, TOF MS, ESI/APCI MS, High Resolution MS
Inorganic and Elemental Analysis
From composition to ultra-trace impurities via XRF, ICP-OES and ICP-MS
NMR and IR Spectroscopy
Multidimensional and quantitative NMR experiments incl. heteronuclei like 11B, 15N, 19F, 29Si and 31P, IR microscopy, imaging & mapping
Enzyme Analysis
Determination of enzyme activities, enzyme identification, storage stability tests
Quality Control
Multiple techniques like TLC, wet chemical values, GPC and more ensure the desired quality
Thermal Analysis and Rheology
Monitoring products properties, e.g. via MDSC, PDSC, (HR)TGA-FTIR and DMA
Surface and Interface Analysis
Microscopic and spectroscopic techniques, e.g. SEM, TEM, AFM, XPS, EDX, XRD, GDOES, CLSM and profilometry
Safety Technology
Different techniques for the classification of goods acc. GHS, REACH physical parameters, burning- and explosion behavior of dust
Sound and Vibration Analysis
Supporting occupational and environmental safety
Control of Measuring Equipment
Laboratory support concerning instrument SOP´s, test procedures and documentation
Radiometry and Thermography
Production and process support, including radiation protection management